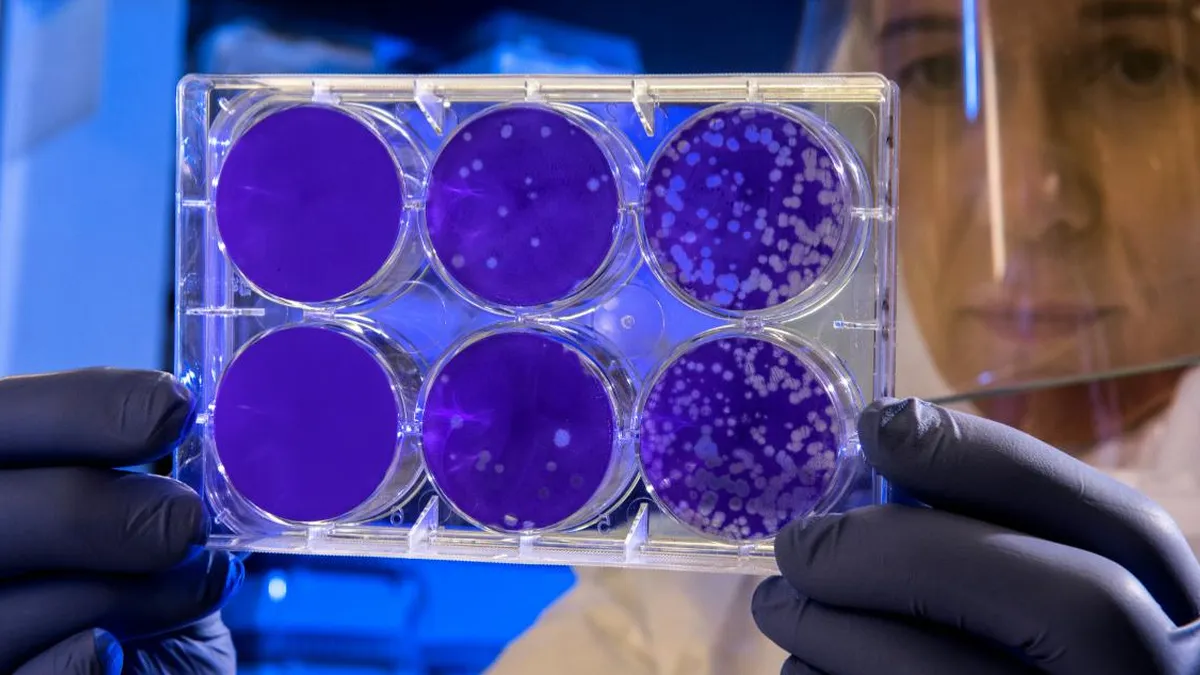
Una IA desentraña el misterio de las superbacterias en solo 2 días.

Una inteligencia artificial (IA) desarrollada por Google ha sorprendido a la comunidad científica al resolver un enigma relacionado con las superbacterias en un tiempo récord de solo dos días. Este avance se refiere a la formulación de una compleja hipótesis que a los investigadores les había tomado años de estudio.
Investigación sobre superbacterias
El microbiólogo José R. Penadés y su equipo del Imperial College de Londres han dedicado una década a investigar cómo se forman algunas superbacterias. Para desarrollar una hipótesis viable, el equipo pasó años realizando investigaciones exhaustivas. En una entrevista con BBC News, Penadés reveló que planteó una pregunta central a la IA sobre su investigación, y en un lapso de 48 horas, recibió la misma respuesta que él había obtenido tras años de trabajo.
Reacción ante el descubrimiento
La sorpresa de Penadés fue tal que se comunicó con Google para averiguar si la IA había tenido acceso a su computadora o a sus datos, dado que su investigación aún no había sido publicada. Sin embargo, la compañía negó cualquier acceso. Además, la IA no solo replicó la hipótesis principal, sino que también propuso otras cuatro alternativas, todas ellas coherentes. Penadés destacó que una de estas hipótesis nunca había sido considerada por su equipo, y actualmente están trabajando en ella.
Hipótesis sobre la propagación de superbacterias
La hipótesis que plantea el experto en microbiología sugiere que las superbacterias, que son gérmenes peligrosos y resistentes a los antibióticos, pueden formar una especie de cola a partir de diferentes virus, lo que les facilita su propagación. Según Penadés, él y su equipo eran los únicos que habían considerado esta posibilidad, y la IA llegó a la misma conclusión. En sus propias palabras, “Estoy ante algo espectacular y estoy muy contento de ser parte de eso”.
Co-scientist: la IA para científicos
La IA en cuestión se denomina “co-scientist” y fue presentada por Google a mediados de febrero. Su objetivo es “ayudar a los científicos a generar nuevas hipótesis y propuestas de investigación, y acelerar la velocidad de los descubrimientos científicos y biomédicos”, según un comunicado de la compañía. Este modelo está diseñado para reflejar el proceso de razonamiento que sustenta el método científico.
Capacidades de co-scientist
El co-scientist va más allá de la simple revisión de literatura científica o la generación de resúmenes. Está destinado a descubrir conocimientos nuevos y originales, así como a formular hipótesis y propuestas de investigación que sean demostrablemente novedosas, basándose en evidencia previa y adaptadas a objetivos de investigación específicos.
El modelo utiliza un conjunto de agentes especializados, que incluyen generación, reflexión, clasificación, evolución, proximidad y meta-revisión, empleando retroalimentación automatizada para generar, evaluar y refinar hipótesis.
Perspectivas sobre el uso de IA en la ciencia
A pesar de que las capacidades de la IA siguen siendo objeto de debate, Penadés expresó su entusiasmo por contar con un apoyo de este tipo, ya que si hubiera logrado formular su hipótesis tan rápidamente como lo hizo el modelo, podrían haberse ahorrado años de investigación. Sin embargo, también existen preocupaciones sobre el uso deliberado de la IA, que algunos consideran podría ser perjudicial o incluso amenazar puestos de trabajo. Penadés concluyó: “Creo que esto cambiará la ciencia, sin duda”.